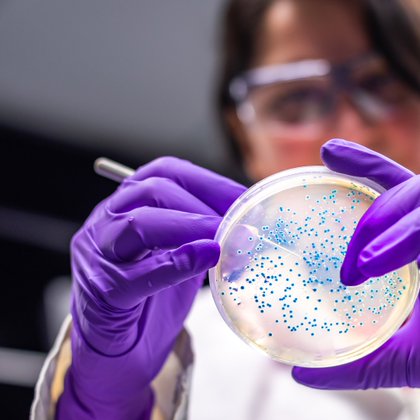
Tweet card summary image

NANOKER RESEARCH
@nanoker
Followers
67
Following
189
Media
18
Statuses
135
Nanoker Research S.L. is a Spanish developer and manufacturer of advanced technical and nanocomposite ceramic products & solutions for top-end applications.
Oviedo, Asturias
Joined November 2020
🗞️Las bacterias resistentes a los antibióticos causan ya más muertes al año que el sida o la malaria @rtve
https://t.co/pgjw7NRsAY
rtve.es
Las bacterias resistentes a los antibióticos causan ya más muertes al año que el sida o la malaria
0
4
4
📷imágenes del transfer de ayer "Innovación en las superficies antimicrobianas" en las próximas horas disponible en YouTube. GRACIAS A : @CamaraOviedo @NanoCINN @CSIC @CSICdivulga #ISPA @HUCA_Asturias @FINBAsturias #virus @nanoker @uniovi_info @precamuniovi
0
3
13
🔴¡En unas horas empezamos! Recuerda que nos puedes ver online a través de : 🔗ZOOM: https://t.co/FiS6NkPg04 🔗YOUTUBE: https://t.co/ykLAcazwQ2
@NanoCINN @CamaraOviedo @nanoker @HUCA_Asturias @FINBAsturias
Hoy a las 12h Serafín Moya y Belén Cabal participarán en el #Transfer de @CSICasturias y @CamaraOviedo sobre superficies antimicrobianas. Hablarán sobre sus recientes descubrimientos acerca de superficies #viricidas
0
4
15
#TransferdelaCámara🚩#Innovación en las #superficiesantimicrobianas 📅20 Ene. ⌚️12.00 h. 💻Formato ONLINE 🔗ZOOM: https://t.co/FiS6NkPg04 🔗YOUTUBE: https://t.co/ykLAcazwQ2
@NanoCINN @nanoker @FINBAsturias #ispa #AST @SCTAsturias @GobAsturias @HUCA_Asturias @UOdivulga
0
7
15
🚩Ya tenemos preparado nuestro 1º #TRANSFER del año 🖊️#Innovación en las #superficiesantimicrobianas 📅20 Ene. ⌚️12.00 h. 💻Formato ONLINE 🔗ZOOM: https://t.co/FiS6NkPg04 🔗YOUTUBE: https://t.co/ykLAcazwQ2
@NanoCINN @nanoker @FINBAsturias #ispa #AST @SCTAsturias @GobAsturias
0
8
11
🎄🛰️Merry Xmas & happy 2022 full of #innovation! Go2Space-HUBs, a reference in the generation of solid local ecosystems for #entrepreneurs & #startups 👉 https://t.co/DtHiVfl6Lh
@parqUC3M @MadridAeroSpace @IPNunes @TechTourHQ @europeunlimited @tehnopol #EUspace @EU_Commission
0
3
3
You can now find Nanoker Research in the Catalogue of Manufacturing and Exporting Companies of @fenin_es , Federación Española de Empresas de Tecnología Sanitaria and @ICEX_. https://t.co/MhQU6E09wY
#ceramics4health #medicaldevice #cadcamdentistry #dentalimplants #bioglass
0
2
2
You can now find Nanoker Research in the Catalogue of Manufacturing and Exporting Companies of @fenin_es , Federación Española de Empresas de Tecnología Sanitaria and @ICEX_. https://t.co/MhQU6E09wY
#ceramics4health #medicaldevice #cadcamdentistry #dentalimplants #bioglass
0
2
2
Buen resumen de lo que compartimos juntos investigadores @uc3m, @AscensoresOtis , @aeq_broadcast y @nanoker @go2space_hubs,moderados por @aiglesiasfraga Gracias @ComunidadMadrid #FEDER por confinanciar esta actividad de @uc3m en colaboración @LeganesPct
#losparquesaportan
Cómo luchar desde la digitalización y la búsqueda de nuevos materiales contra la crisis de suministro industrial Investigadores y empresas debaten en un evento del @parqUC3M los retos y oportunidades tecnológicas en el entorno industrial #LIVEparqueUC3M
0
6
6
One of our accelerated #startups participated yesterday in the "R+D+i challenges 2021" @parqUC3M virtual event: @nanoker produces & commercializes high performance ceramic components based on advanced ceramics, #nanoceramics and #nanocomposites 👉
Pasamos a la mesa de innovación y práctica empresarial con: Gianluca Foschini, responsable de innovación @AscensoresOtis Europa, multinacional en @PTLeganes Iván Olmeda, CEO de #AEQ (en @PTLeganes) Sergio Rivera, CTO de @nanoker, startup del programa @go2space_hubs @uc3m
0
5
5
Mañana comienza la feria virtual en vivo “imPrYME Conocimiento”, que tendrá lugar los días 17 y 18 de noviembre de 2021 Descubre cómo pueden ayudar a que tu PYME sea más competitiva a través de la innovación Registro ⬇️ https://t.co/9qxMDSZpOX
@DLGMA_CSIC @CSICmasI
0
3
3
Evento de Retos en I+D+i 2021: La #Fábrica 5.0 busca la relocalización y nuevos materiales Con #investigadoresUC3M y representantes de las empresas @AscensoresOtis, @nanoker y #AEQ Inscripciones (𝗵𝗼𝘆 𝘂𝗹𝘁𝗶𝗺𝗼 𝗱𝗶𝗮): https://t.co/BWCOoaP36i ➡️ https://t.co/JUv70H2ytl
0
4
9
Pasamos a la mesa de innovación y práctica empresarial con: Gianluca Foschini, responsable de innovación @AscensoresOtis Europa, multinacional en @PTLeganes Iván Olmeda, CEO de #AEQ (en @PTLeganes) Sergio Rivera, CTO de @nanoker, startup del programa @go2space_hubs @uc3m
0
1
4
You can now find @nanoker in the Catalogue of manufacturing and exporting companies of medical technology from Spain with the support of @fenin_es and @ICEX_
https://t.co/DXPhq1579s
0
1
3
You can now find @nanoker in the Catalogue of manufacturing and exporting companies of medical technology from Spain with the support of @fenin_es and @ICEX_
https://t.co/DXPhq1579s
0
1
3
Evento virtual #LIVEparqueUC3M: La Fábrica 5.0 busca la relocalización y nuevos materiales 💡 🗣️ Con la participación de #investigadoresUC3M y representantes de las empresas @AscensoresOtis, @nanoker y #AEQ 🗓️Hoy, día 16, desde las 09:30h ℹ️ Más info: https://t.co/Gjcjh34RvR
0
3
5
El CSIC lanza la feria virtual #Impryme para impulsar la innovación tecnológica en las pymes. El evento, el 17 y 18 de noviembre, será un gran punto de encuentro de la ciencia con las empresas en áreas de biomedicina, cambio climático y nuevos materiales. https://t.co/2LlgYjE60x
2
21
44
Nuevo #Reto I+D+i 2021: 𝗟𝗮 𝗙𝗮𝗯𝗿𝗶𝗰𝗮 𝟱.𝟬 𝗯𝘂𝘀𝗰𝗮 𝗹𝗮 𝗿𝗲𝗹𝗼𝗰𝗮𝗹𝗶𝘇𝗮𝗰𝗶𝗼𝗻 𝘆 𝗻𝘂𝗲𝘃𝗼𝘀 𝗺𝗮𝘁𝗲𝗿𝗶𝗮𝗹𝗲𝘀 Con participación de investigadores @uc3m y propuestas innovadoras de @AscensoresOtis, @nanoker y #AEQ ➡️ + información: https://t.co/JUv70H2ytl
0
7
9
Everything is ready for the 2nd day of our International Investment and Partnering Final Event https://t.co/Q3AWXPFMPk
@TechTourHQ @parqUC3M @IPNunes @tehnopol @MadridAeroSpace #EUspace @EU_Commission #entrepreneurs #startups #StartupSpace
0
2
3
🔴📢Acompaña a @go2space_hubs en un evento para conocer a las 45 empresas más relevantes del sector #espacio. 10 de ellas incubadas y aceleradas por el programa Go2Space-HUBs coordinado desde la @uc3m @parqUC3M. Hoy y mañana➡️ https://t.co/i2eOcYvymk
#LosParquesAportan
0
4
4